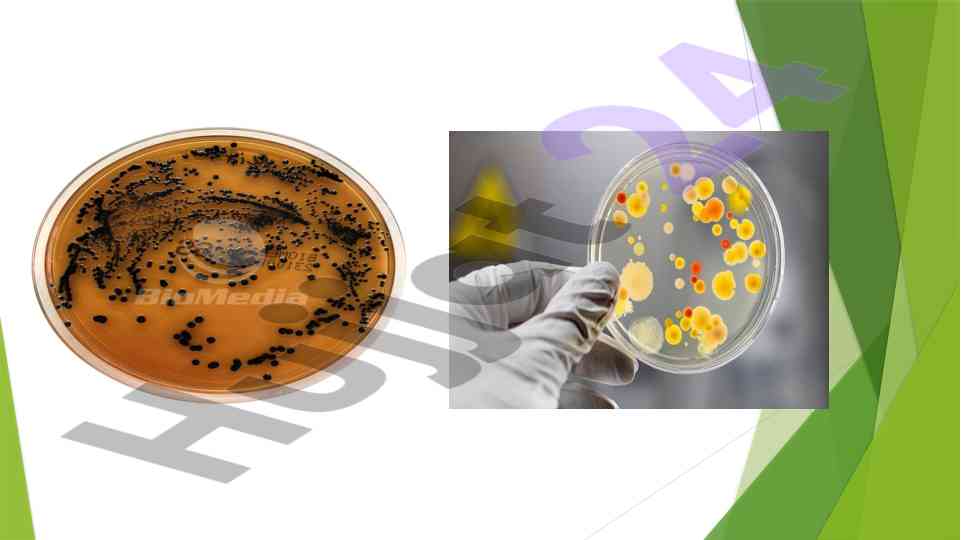

Ovqatdan zaharlanish yuqumli kasallik qoʻzgʻatuvchilari

Hu
Muallif:
Hujjat Sifati
Hujjat ma'lumotlari
Kategoriya:
Taqdimotlar (slaydlar) Format:
pptx Sahifalar:
37 bet Ko'rilgan:
0 marta Sotilgan:
0 marta Hajmi:
1.00 MB Narxi:
5,000 so'mMahsulot tavsifi:
Ovqatdan zaharlanish va uning laboratoriya tashxisi haqida ilmiy maqola. Kasalliklar va xavfli mikroblar turli oziq-ovqat mahsulotlarida qanday paydo bo'lishi, ularning sabablari va belgilari.